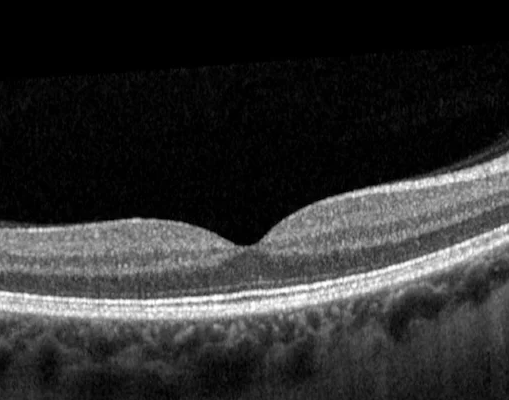

Präzise Auswertung medizinischer Bildgebung, um Augenkrankheiten frühzeitig zu erkennen und fundierte Diagnosen zu unterstützen.

Schnell und effizient – wir bieten Diagnosen und Empfehlungen aus der Ferne, basierend auf detaillierten Bild- und Befundanalysen.
Schnell und effizient – wir bieten Diagnosen und Empfehlungen aus der Ferne, basierend auf detaillierten Bild- und Befundanalysen.
Unser virtuelles Auswertungszentrum bietet Ihnen eine Vielzahl spezialisierter Dienste für die Analyse und Bewertung ophthalmologischer Befunde